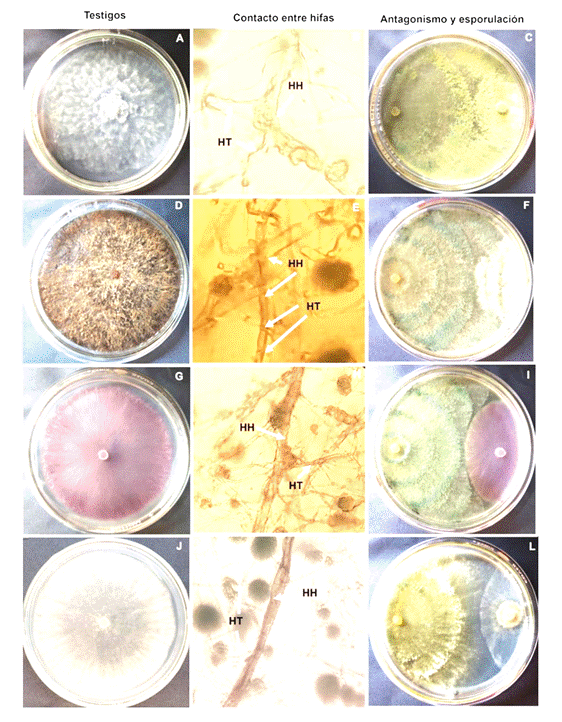

Introducción
Varios cultivos de importancia económica enfrentan problemas fitosanitarios debido a la presencia de enfermedades causadas por P. capsici, R. solani, B. cinerea y F. oxysporum (Andrade-Hoyos et al., 2019; Cheung et al., 2020). Estos microorganismos causan enfermedades en una amplia gama de hospedantes a nivel mundial, los cuales afectan todas las partes de la planta, incluyendo corona, raíces y frutos (Parada-Rojas et al., 2021). Su capacidad para permanecer inactivos en condiciones desfavorables hace que sean difíciles de controlar (Senapati et al., 2022). Por tal motivo, es recomendable que las plantas sean protegidas desde semillero hasta el trasplante. En estas etapas, la aplicación de fungicidas se ha vuelto indispensable para controlar enfermedades fungosas (González et al., 2021). Sin embargo, el uso excesivo de estos representa un riesgo para el ambiente y suelo, ya que reduce la actividad microbiológica y bioquímica, además, varios organismos han generado resistencia y los fungicidas dejan de ser funcionales (Baćmaga et al., 2019; Samal et al., 2023). Una alternativa ecológica es usar agentes de biocontrol como Trichoderma spp. que tienen actividad micoparasitaria, competitividad por espacio, nutrientes y han mostrado antagonismo en al menos 29 especies de hongos asociados con enfermedades en plantas (Geng et al., 2022; Guzmán-Guzmán et al., 2023).
Se ha demostrado que T. afroharzianum inhibe a R. solani, F. oxysporum, P. capsici y B. cinerea (Mokhtari et al., 2017; Mokhtari, 2018; Zhao et al., 2021). Sin embargo, se ha reportado como patógeno de cereales (Pfordt et al., 2023). Por lo tanto, su aplicación se centra en otras especies de interés hortícola u ornamental, además, el comportamiento de estas especies varía dependiendo de la región geográfica de donde provienen los aislados (Miranda, 2022), de ahí radica la importancia de su evaluación.
Por otra parte, algunas sustancias homeopáticas se proponen como posibles insumos antifúngicos, hasta la fecha son escasos los estudios sobre aceites esenciales homeopáticos donde se demuestre su efectividad, estudios como el de Oliveira et al. (2017) han demostrado que el aceite esencial homeopático de Eucalyptus citriodora y Cymbopogon citratus disminuyen la germinación de Alternaria solani y Corynespora cassiicola. Las sustancias homeopáticas son seguras y de bajo costo, lo cual representa una opción sostenible; no obstante, se debe evaluar su efecto sobre otros hongos y sobre agentes de biocontrol como T. afroharzianum, en vista de que algunas especies del género Tagetes tienen efecto fungistático (Serrato et al., 2014). Se propone la evaluación de homeopáticos derivados del aceite esencial de Tagetes remotiflora, T. arenicola y T. lucida, aspecto que permitirá definir la compatibilidad de la aplicación conjunta y uso de estas sustancias para futuras evaluaciones con otros microorganismos. El objetivo del estudio fue evaluar el antagonismo de T. afroharzianum y sustancias homeopáticas contra cuatro hongos asociados a enfermedades de importancia hortícola.
Se usaron cepas identificadas de manera molecular (Ruíz-González et al., 2024) con registro GenBank: T. afroharzianum (PP843541.1), F. oxysporum (PP729638.1), R. solani (PP713022.1), P. capsici (PP922286.1) y B. cinerea (PP401673.1), del laboratorio de resistencia genética de la Universidad Autónoma Chapingo (Texcoco, México). La cepa T. afroharzianum fue aislada de muestras de suelo provenientes de La Cabaña, Acaxochitlán, Hidalgo (N 20° 08’ 43.63’’ E 98° 09’ 37.32’’). Los hongos fueron reactivados en medio de cultivo agar dextrosa y papa (PDA). Después se evaluó el antagonismo mediante la técnica de cultivo dual en PDA. Con un sacabocados de 3.5 mm de diámetro se obtuvieron discos con inóculo del antagonista y los hongos, todos tenían cinco días de edad y se colocaron a
2 cm de distancia de ambos bordes de las cajas Petri. Se utilizaron cuatro repeticiones por cada tratamiento. Los testigos fueron cajas Petri con cultivos individuales de cada hongo. La incubación en oscuridad para cada organismo fue 22 °C para B. cinerea y 25 °C para F. oxysporum, R. solani y P. capsici. Cada 24 h se midió el crecimiento micelial en la misma dirección de crecimiento hasta que los testigos sin antagonista cubrieron totalmente la caja Petri. La variable inhibición se estimó con la fórmula utilizada por Ezziyyani et al. (2004). El antagonismo se determinó con la escala siguiente: 1. El antagonista crece sobre el hongo y cubre 100 % de la caja Petri; 2. El antagonista cubre 75 % de la caja Petri, detiene al hongo y puede crecer y esporular sobre él; 3. Ningún organismo es dominante, cada uno cubre 50 % de la superficie (antagonista y hongo); 4. El hongo cubre 75 % de la caja Petri y detiene el crecimiento del antagonista y puede crecer y esporular sobre este; y 5. El hongo crece sobre el antagonista y cubre 100 % de la caja Petri (Bell et al., 1982).
Los aceites esenciales homeopáticos fueron elaborados por el Dr. Felipe de Jesús Ruíz Espinoza (Profesor-investigador) del Centro Regional Universitario del Anáhuac de la Universidad Autónoma Chapingo. Se utilizó la escala centesimal (CH: centesimal Hahnemanniana), en un frasco ámbar se colocaron 99 gotas de alcohol etílico (4.95 mL) y una gota de aceite (0.05 mL). Posteriormente, se realizó la sucusión como lo indica Maldonado et al. (2015) y se obtuvo la dilución 1CH. A partir de la dilución 1CH se tomó 1 gota (0.05 mL) y se agregaron 99 gotas de alcohol, se repitió el proceso de sucusión y se obtuvo la dinamización 2CH y así sucesivamente hasta la dinamización 6CH y 200 CH evaluadas en este estudio (Maldonado et al., 2015). Los homeopáticos se prepararon de forma individual para cada especie: T. remotiflora (6CH-R y 200CH-R), T. arenicola (6CH-A y 200CH-A) y T. lucida (6CH-L y 200CH-L) en dinamizaciones 6CH y 200CH. En matraces Erlenmeyer de 250 mL se preparó medio PDA (100 mL) combinado con 10 gotas (0.5 mL) de sustancia homeopática (cada sustancia homeopática se preparó por separado). Resultaron seis tratamientos diferentes de sustancias homeopáticas (6CH-R, 6CH-A, 6CH-L, 200CH-R, 200CH-A, 200CH-L) y un testigo sin los homeopáticos. Cada tratamiento fue evaluado de forma individual para cada hongo. Después, el inóculo de los hongos se colocó en el centro de las cajas Petri y posterior incubación como se indicó anteriormente. En esta etapa las sustancias homeopáticas se evaluaron como un posible insumo antifúngico por lo que no se evaluó en el cultivo dual. Cada 24 h se midió crecimiento (mm día-1) de los microorganismos. Los experimentos se hicieron bajo un diseño completamente al azar con cuatro repeticiones y los datos fueron sometidos a análisis de varianza y prueba de medias Tukey (α=0.05) en SAS OnDemand for Academics.
T. afroharzianum mostró inhibición superior al 67 % sobre B. cinerea y P. capsici, lo cual fue estadísticamente diferente con respecto a lo observado con F. oxysporum (63 %). En R. solani la inhibición fue del 64 %, sin diferencias estadísticas (Figura 1). En este estudio la inhibición de B. cinerea fue 13 % mayor (Figura 1) con respecto a lo observado por Zhao et al. (2021) al utilizar los mismos hongos. Esto podría deberse porque T. afroharzianum ayuda a degradar el ácido oxálico, que es un factor patogénico de B. cinerea (Wu et al., 2022). La inhibición reportada de T. afroharzianum sobre R. solani, F. oxysporum y P. capsici ha sido de 98, 95 y 84.7 %, respectivamente (Mokhtari et al., 2017; Mokhtari, 2018), con esto se puede observar que T. afroharzianum puede responder de manera diferente con los mismos hongos. En perspectiva la evaluación in vivo es una siguiente fase para corroborar el antagonismo de T. afroharzianum, ya que especies del mismo género se han caracterizado por promover el crecimiento de las plantas, mejorar la eficiencia de utilización de nutrientes y mejorar su resistencia (Yao et al., 2023).

Figura 1 Inhibición del crecimiento micelial de B. cinerea (5 días), P. capsici (11 días), R. solani (8 días) y F. oxysporum (9 días) debido al efecto de T. afroharzianum, bajo condiciones in vitro. Media ± desviación estándar (n=4) con diferentes letras son estadísticamente diferentes (Tukey, p≤0.05).
El crecimiento micelial de T. afroharzianum fue dos veces mayor cuando creció solo (TO) (Figura 2). A partir del segundo día se observaron diferencias estadísticas comparado con el crecimiento que tuvo cuando creció junto a los otros hongos (cultivo dual) (Figura 2). Esto puede deberse a que algunos hongos producen metabolitos bioactivos como pigmentos, antioxidantes, polisacáridos y enzimas que pueden interferir en el crecimiento de otros organismos (Shankar y Sharma, 2022).

Figura 2 Crecimiento micelial in vitro (mm) de T. afroharzianum en cultivo dual contra B. cinerea (B), R. solani, (R), P. capsici (P) y F. oxysporum (F). TO: testigo, T: T. afroharzianum, Media ± desviación estándar (n=4) con diferentes letras son estadísticamente diferentes (Tukey, p≤0.05).
El contacto hifal entre B. cinerea, P. capsici y F. oxysporum se observó al cuarto día y en R. solani al tercer día (Figura 3). En todos los casos, T. afroharzianum (antagonista) detuvo el crecimiento de los hongos. La interacción entre P. capsici y T. afroharzianum (Figura 2 y 3) mostró antagonismo tipo uno, el antagonista creció sobre P. capsici, deformó sus hifas y cubrió totalmente la caja Petri (Figura 3). En R. solani y B. cinerea se observó antagonismo tipo dos, donde el antagonista cubrió 75 % de la caja Petri, detuvo el crecimiento de R. solani y B. cinerea y esporuló sobre estos (Figura 3). En F. oxysporum se observó antagonismo tipo tres, a pesar de que T. afroharzianum tuvo mayor crecimiento (Figura 2) no fue capaz de crecer sobre F. oxysporum (Figura 3). El micoparasitismo observado (Figura 3) puede deberse porque Trichoderma spp. secreta compuestos fitotóxicos y enzimas degradantes de la pared celular, cuando estas enzimas degradan las paredes celulares de los hongos, se liberan oligómeros, lo que provoca la inducción de otros compuestos fitotóxicos y enzimas degradantes (Mukherjee et al., 2012). Cheng et al. (2012) mencionan que el proceso micoparasitario de Trichoderma spp. implica dos pasos; una etapa inicial de enrollamiento de hifas y una etapa de enrollamiento de hifas posterior, con diferentes velocidades de enrollamiento.
Figura 3 Crecimiento micelial (mm) individual de testigos: P. capsici (A), R. solani (D), F. oxysporum (G) y B. cinerea (J) y antagonismo en el cultivo dual al momento de contacto entre hifas (B, E, H, K) y esporulación luego que los testigos cubrieron la caja Petri (C, F, I, L). HH: hifas de hongos, HT: hifas de T. afroharzianum.
Por otro lado, la sustancia homeopática 6CH de T. remotiflora (6CH-R) disminuyó el crecimiento de F. oxysporum, R. solani y T. afroharzianum, mientras que el homeopático 200CH de T. arenicola (200CH-A) estimuló el crecimiento de B. cinerea, P. capsici y T. afroharzianum (Figura 4). P. capsici mostró mayor crecimiento con todas las sustancias homeopáticas. Finalmente, T. afroharzianum tuvo mayor crecimiento con los homeopáticos 6CH-A y 200CH-A. Oliveira et al. (2017) evaluaron homeopáticos 6, 12, 30, 60, 100 y 200CH derivados de aceites esenciales de E. citriodora y C. citratus y todas las dinamizaciones redujeron la germinación de A. solani y C. cassiicola. En este estudio la dinamización 6CH también inhibió a F. oxysporum, R. solani y T. afroharzianum (Figura 4). Con respecto a efectos estimulantes con aceites esenciales, Ćosić et al. (2010) y Simas et al. (2017) observaron estimulación de Fusarium subglutinans y Penicillium digitatum con aceite esencial de Rosmarinus officinalis y con (-) limoneno y γ-terpineno, respectivamente. También, homeopáticos 12, 24, 30 y 60CH elaborados a partir de Corymbia citriodora y aceite de Eucalyptus sp. tuvieron efectos estimulantes sobre los mecanismos de defensa en plantas de Phaseolus vulgaris var. Carioca (Oliveira et al., 2014). Esto se observó con la sustancia homeopática T. arenicola (200CH-A) ya que también estimuló el crecimiento de los hongos (B. cinerea, P. capsici y T. afroharzianum).

Figura 4 Dinámica de crecimiento fúngico por el efecto de sustancias homeopáticas en B. cinerea, P. capsici, F. oxysporum, R. solani y T. afroharzianum. CH: centesimal hahnemanniana, R: T. remotiflora, L: T. lucida, A: T. arenicola. Media ± desviación estándar (n=4) con diferentes letras son estadísticamente diferentes (Tukey, p≤0.05).
La inhibición y antagonismo notable de T. afroharzianum contra P. capsici, R. solani y B. cinerea, así como la capacidad para crecer y esporular sobre estos confirma su efectividad como un importante agente de control biológico y candidato para realizar futuras evaluaciones in vivo. Por otra parte, aunque las sustancias homeopáticas no mostraron un efecto definido, la sustancia homeopática 200CH-A de T. arenicola estimuló el crecimiento de T. afroharzianum (25.15 vs 22.86 mm del testigo), un antecedente importante para estudios posteriores. Aunque hubo inhibición de algunas sustancias homeopáticas (6CH-R) sobre F. oxysporum, R. solani y T. afroharzianum, habrá que prestar mucha importancia al uso de estas, ya que también promovieron (200CH-A) el crecimiento micelial de P. capsici y B. cinerea.











 texto en
texto en 


